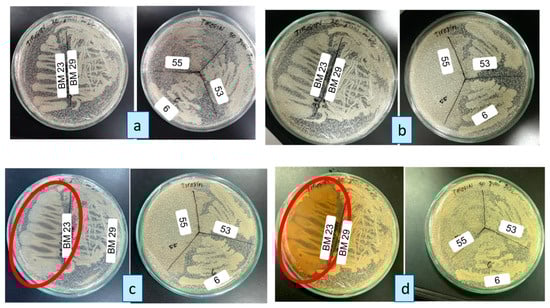

Abstract
This work describes the development of an electrochemical biosensor method based on bacterial consortia to determine antioxidant capacity. The bacterial consortium used is a combination of bacteria from the genera Bacillus and Pseudomonas which can produce the enzymes tyrosinase and laccase. The consortium bacteria were immobilized on the surface of the screen-printed carbon electrode (SPCE) to form a biofilm. Biofilms were selected based on the highest current response evaluated electrochemically using cyclic voltammetry analysis techniques. Optimum consortium biofilm conditions were obtained in a phosphate buffer solution of pH 7, and biofilm formation occurred on day 7. This work produces analytical performance with a coefficient of determination (R2) of 0.9924. The limit of detection (LOD) and limit of quantification (LOQ) values are 0.5 µM and 10 µM, respectively. The biosensor showed a stable response until the 10th week. This biosensor was used to measure the antioxidant capacity of five extracts, and the results were confirmed using a standard method, the 2,2-diphenyl-1-picrylhydrazyl (DPPH) method. The highest antioxidant capacity is guava extract and the lowest is tempuyung extract. Thus, the development of this biosensor method can be used as an alternative for measuring antioxidant capacity.
1. Introduction
Consuming fast food, excessive stress, air pollution, and alcoholic beverages can cause oxidative stress in the body, followed by the emergence of degenerative diseases, such as liver, heart cancer, diabetes, and others. For this reason, a healthy lifestyle and environment play an essential role in protecting the body from disease. Minor changes to start a healthy life can be initiated by consuming antioxidant compounds to inhibit free radicals and maintain a balance between the amount of oxidants and pro-oxidants in the body [1]. The antioxidant ability of phenolic compounds depends on the number and arrangement of hydroxyl groups in the ring structure. Polyphenols can be found in flavonoid and phenolic acid compounds sourced from food or drinks, vegetables, fruit, nuts, herbs, spices, and plants. Several plants that contain antioxidants include Orthosiphon stamineus, Curcuma xanthorriza, Sonchus arvensis, Psidium guajava, and Phyllanthus niruri [2,3,4,5]. Several studies have been carried out to detect antioxidant capacities, such as the research conducted by Lilian et al. [6] on medium roast coffee, and the highest antioxidant content was 1.07 mg/g (equivalent to Trolox equivalent antioxidant capacity); apart from that, the research carried out by Zhang et al. [7] on phenolics in pomaces ranged from 137 to 221 mg/g and in juices ranged from 2.75 to 8.88 mg/g.
Generally, the analytical techniques used to measure polyphenol antioxidants are spectrophotometry, fluorescence chromatography, liquid or gas chromatography, and reverse-phase high-performance liquid chromatography with ultraviolet or electrochemical detection [8,9,10,11]. These analytical techniques have disadvantages, such as expensive analysis costs and complex sample preparation [12]. Based on the shortcomings of these analytical techniques, it is necessary to develop new methods as an alternative for measuring antioxidant capacity. One method that can be developed is biosensors. A biosensor is a measurement method using biological components as receptor elements for changes in analytes and transducers to produce signals. Biological components can be enzymes, antibodies, DNA, cells, and microorganisms, peptides, and biopolymers [13,14,15]. This method has advantages, including providing rapid detection, being simple, portable, reasonably valid, miniaturized, and having low analysis costs [16,17]. Antioxidant analysis in biosensors usually uses the enzymes peroxidase [18], tyrosinase [19], and laccase [20]. Using more than one enzyme in the same detection system leads to bi-enzymatic biosensors or multi-enzyme sensors.
Pure enzyme-based electrochemical biosensors are expensive due to the need for enzyme isolation, relatively short shelf life, and low stability. Therefore, bacteria are used as enzyme-producing bioreceptors. The bacteria are immobilized on a screen-printed carbon electrode (SPCE) to form a biofilm. Examples of bacteria that can be used as bioreceptors are from the genera Bacillus and Pseudomonas [21]. The development of a biosensor based on bacteria that produces this enzyme has been carried out by several researchers, such as Wijayanti [22], who reported that a biosensor based on the superoxide dismutase (SOD) enzyme from D. radiodurans obtained high current at the optimum conditions for each electrode, and then Iswantini et al. [23] also used the bacterium D. radiodurans as a bioreceptor, which was immobilized on a zeolite nanocomposite modified electrode.
Montereali et al. [24] developed a bi-enzyme biosensor using the tyrosinase–laccase enzyme immobilized on a ferrocene-modified graphite electrode to detect phenolic compounds in alcoholic beverage samples. However, there are still few studies that use bi-enzymes in measuring the antioxidant capacity of a sample. There are several advantages to using two or more enzymes, including combining several enzymes, which can increase the sensitivity of the biosensor. Multianalyte biosensors can offer the opportunity to conduct rapid and cost-effective analysis with unique samples. Additionally, a reduction in the physical size of the device is desirable; having one electrode with two or more enzymes reduces space and materials used [25], and increasing productivity by eliminating isolation steps allows susceptible multi-enzyme systems for analyte detection [26]. Therefore, this research developed a biosensor based on a consortium of bacteria as a bioreceptor producing tyrosinase and laccase enzymes to detect antioxidant polyphenolic compounds and compare the results with reference methods. The stages of this research include screening for tyrosinase and laccase enzymes, bacterial physiological tests, manufacturing and screening consortium biofilms, optimizing and evaluating the analytical performance of consortium biofilms, and determining antioxidant capacity using biosensors.
2. Materials and Methods
2.1. Materials and Reagens
The equipment used was a Sanyo MIR-162 incubator, Hirayama HVE 50 autoclave, CVB 1300 M laminar air flow, 1000 μL and 10 μL micropipettes (Eppendorf, Hamburg, Germany), TOA DK HM-250 pH meter, 5415C centrifuge, microtubes, SPCE DRPCAC71190 Metrohm connector (DropSens, Asturias, Spain), potentiostat/galvanostat (eDAQ, New Zealand, Australia) with three-electrode system (eDAQ, New Zealand, Australia), screen-printed carbon electrode (Dropsens, Asturias, Spain), a computer equipped with the data processing program Echem v.2.1.0, Design Expert-13 (Minneapolis, MI, USA), and Origin Pro 8.5, (OriginLab, Northampton, MA, USA), scanning electron microscope (SEM) (HITACHI TM3030, Oklahoma, Japan), SmartstatXL ver. 3.5.1.0 (Jatinangor, Indonesia), Image-J (Bethesda, MD, USA), and chemical laboratory glassware (Duran, Pyrex, and Iwaki).
All materials used in this research were purchased from Sigma-Aldrich. Commercial extracts of Psidium guajava (guava), Curcuma xanthorriza, Phyllanthus niruri, Sonchus arvensis, and Orthosiphon stamineus were obtained from PT Biofarmaka, Indonesia. The bacteria used in this research were obtained from the Microbiological Recovery Research Laboratory, BRIN Cibinong, Indonesia.
2.2. Bacterial Culture and Bacterial Physiological Tests
Bacillus megaterium bacterial isolates were grown and rejuvenated using the scratch plate method on heterotrophic media, and Pseudomonas isolates were grown on Pseudomonas isolation agar (PIA) media and then incubated for 24 h at 37 °C. Heterotrophic media were made from a mixture of 3.0 g agar, 3.6 g tryptone, 1.0 g NaCl, and 0.5 g K2HPO4 dissolved in 200 mL of distilled water. Next, media sterilization was carried out in an autoclave for 15 min at a temperature of 121 °C. After that, 10 to 15 mL of warm heterotrophic media was poured into a Petri dish and left to cool and solidify on a sterile worktable equipped with UV light. The solidified media were then ready to grow and rejuvenate bacterial cells. PIA media are made from 6 g of PIA powder dissolved in 200 mL of distilled water and stirred until homogeneous in the microwave. Next, the media were sterilized by autoclaving for 15 min at 121 °C. After that, 10 to 15 mL of warm heterotrophic media was poured into a Petri dish and then left to cool and solidify on a sterile worktable using UV light. The solidified media were then ready to be used to grow and rejuvenate bacterial cells. Then, bacterial physiological tests were carried out, such as Gram staining and catalase and oxidase tests to ensure a comprehensive understanding of the bacterial isolates.
2.3. Screening for Bacteria Producing Tyrosinase and Laccase Enzymes
The enzyme screening process was conducted with utmost thoroughness. Tyrosinase enzyme screening was carried out on tyrosine media using the L-tyrosine compound. Laccase enzyme screening was carried out using Pseudomonas bacteria in laccase media with the addition of guaiacol and CuSO4 compounds. Expression of laccase activity was carried out on Luria Agar containing 24 g/L yeast extract, 20 g/L tryptone, 0.4% glycerol, 0.017 M KH2PO4, and 0.072 M K2HPO4 with 100 g/mL ampicillin supplemented with 0.01% (w/v) guaiacol as laccase substrate and 0.35 mM CuSO4 [27]. The method for testing laccase activity involved strains being grown and rejuvenated overnight at 37 °C, and the formation of a brown zone around the colonies when the tested reagent produced laccase was observed. Bacterial isolates were grown on solid agar media, which had the following composition: yeast extract (0.15%), tryptone (0.15%), NaCl (0.5%), L-tyrosine (0.1%), and agar (3%), dissolved in 100 mL of distilled water [28].
2.4. Biofilm Formation
Bacteria selected from physiological tests were grown in liquid media and then incubated using a water bath shaker for 3–4 h with a temperature of 37 °C. Then, the bacteria were harvested by centrifugation speed 10,000 rpm for 5 min. The bacterial pellets were rinsed three times using phosphate-buffered saline (PBS) with a pH of 7.4. After that, the bacteria were dropped on the surface of the screen-printed carbon electrode. Immobilization of the consortium bacteria to become a biofilm was carried out in 3 different ways: the first was to drop 10 µL of Bacillus bacteria and then 10 µL of Pseudomonas bacteria until the total drop was 100 µL. In the second method, 10 µL of Pseudomonas bacteria is dropped, followed by 10 µL of Bacillus, wait until it dries, and then repeat the treatment up to 100 µL. The first and second methods are called external mixing. The third method (internal mixing) is that the bacteria are first mixed with Bacillus and Pseudomonas bacteria into a microtube with a ratio of 1:1, homogenized using a vortex, and then dripped onto the SPCE surface in 20 µL increments up to 100 µL; then, for all methods, 0.1% agar solution is added (temperature ±40–50 °C), as much as 10 µL. The number of bacterial colonies produced in the drop of 10 μL by B. megaterium 23 was 2 × 105 cfu/mL, P. fluorescens P4 was 119 × 105 cfu/mL, P. fluorescens P5 was 232 × 105 cfu/mL, and P. fluorescens P7 was 312 × 105 cfu/mL. The consortium biofilm formation scheme is shown in Figure 1.

Figure 1.
The consortium biofilm formation scheme.
2.5. Biofilm Selection and Electrochemical Measurement of Biosensors
Select the bacterial biofilm to be used, namely single Bacillus bacterium, single Pseudomonas, and bacterial consortium using three different immobilization methods described previously. The analyte used for biofilm selection was ascorbic acid with a concentration of 0.05 M dissolved in pH 7 of the PBS solution. Measurement of antioxidant compounds was performed using a potentiostat (eDAQ, New Zealand, Australia) with a cyclic voltammetry (CV) technique equipped with Echem v2.1.0 software. Current measurements use window parameters of −1000 mV initial potential, final potential −1000 mV, scan rate of 100 mV/s, and three number of cycles.
2.6. Optimization and Characterization of Consortium Biofilms
Biofilm optimization was carried out using a combination of PBS pH factors (6–8) and biofilm formation time (3–12 days). The method used was response surface methodology and central composite design (CCD) with Design Expert-13 software. The consortium bacteria that were immobilized on the SPCE surface were stored in a container at room temperature. The morphology of the consortium biofilm on the SPCE surface was characterized using scanning electron microscopy (SEM).
2.7. Evaluation of the Analytical Performance of Biosensors
Analytical performance parameters measured include linearity, sensitivity, limit of detection (LOD), limit of quantitation (LOQ), selectivity, replicability, and measurement stability. Linearity of catechol measurements was carried out over a concentration range (10−300 µM). Replicability was tested by measuring catechol solutions of specific concentrations using 5 individual SPCEs. The replicability value is known from the % RSD produced. The stability of the consortium biofilm was tested using 1 SPCE, which was used repeatedly in different weeks.
2.8. Measurement of Antioxidant Capacity Using Biosensor
Measurement of antioxidant capacity using a biosensor refers to the method by Campanella et al. [29], which has been modified. Biosensor measurements were carried out with 1 mL of catechol as a substrate, which was added in concentration gradually, and with each addition, the resulting change in current was measured. Next, the measurements were repeated by adding 0.5 mL of ascorbic acid as a standard compound with varying concentrations of 100, 50, 25, 12.5, and 6.25 ppm and commercial extract samples. Antioxidant capacity can be calculated as relative antioxidant capacity (RAC) in Equation (1) [30].
Note:
- mA: slope without added extract.
- mB: slope with added extract.
2.9. Determination of Antioxidant Capacity by DPPH Method
Measurement of antioxidant capacity was also carried out using the standard method, namely DPPH. Determination of antioxidant capacity was tested on the five extract samples. A total of 40 µL of the extract solution was put into a 96-well plate, and 250 µL of DPPH solution (5 mg DPPH in 100 mL ethanol) was added and then incubated in the dark for 30 min measured at a wavelength of 517 nm [7]. Ascorbic acid was used as a standard with varying concentrations of 100, 50, 25, 12.5, and 6.25 ppm. Antioxidant capacity was expressed as millimolar ascorbic acid equivalents in g extract (mmol AAE/g extract). The scheme for determining antioxidant capacity by biosensor and DPPH method is shown in Figure 2.

Figure 2.
Scheme determination of antioxidant capacity by biosensor and DPPH method.
2.10. Data Analysis
Cyclic voltammetry data from the potentiostat were processed and analyzed using Echem v 2.1.0, Origin Pro 8.5, and Microsoft Excel 2013 applications. Data were acquired from the comparison of DPPH and biosensor methods using ANOVA on the SmartstatXL application ver 3.5.1.0 (Jatinangor, Indonesia).
3. Results and Discussion
3.1. Bacterial Culture and Bacterial Screening of Bacillus megaterium and Pseudomonas sp., Pseudomonas fluorescens, Pseudomonas aeroginosa
This research used 12 bacterial isolates, specifically from Bacillus megaterium and Pseudomonas sp., Pseudomonas fluorescens, and Pseudomonas aeruginoasa. These isolates, each with unique names and codes, can produce tyrosinase and laccase enzymes. The B. megaterium isolates were inoculated on solid heterotrophic media. At the same time, the Pseudomonas bacteria were similarly treated on PIA media, containing essential carbon and nitrogen sources for bacterial growth and forming pure colonies. The media used had been meticulously sterilized to ensure the absence of any unwanted microbes, demonstrating our commitment to maintaining the purity of our bacterial cultures. The results of our bacterial cultivation revealed milky white bacterial morphology and irregular bacterial colonies.
The results obtained from the physiological test of bacteria from Gram staining, namely all Bacillus megaterium including Gram-positive bacteria, which are marked with a purple color at the time of observation, and all Pseudomonas sp., P. aeroginosa, and P. fluorescens, including Gram-negative bacteria, which are marked with a red color at the time of observation using a microscope. Based on the results of the oxidase test on 12 bacterial isolates, all bacteria showed positive results as indicated by a blue-violet color change except code 21; this occurred because the bacteria were probably inactive due to temperature and storage time. The results of this research align with those of Panjaitan et al. [31], who state that the color change to blue in bacteria indicates that the bacteria have the oxidase enzyme. The results of the catalase test indicated that all bacterial isolates positive for catalase were marked by the formation of gas bubbles, which is in line with the research by Damayanti et al. [32] that the bacterial isolate obtained reacted positively in the catalase test due to the breakdown of H2O2 into O2, while another bacterial isolate reacted negatively in the catalase test because there was no breakdown of H2O2 into O2
3.2. Tyrosinase and Laccase Enzyme Screening
3.2.1. Tyrosinase Enzyme Screening
Enzyme-producing bacteria are widely used because they quickly cultivate and easily control their growth. The bacteria used to screen the tyrosinase enzyme in this study were B. megaterium with a different isolate code. B. megaterium bacteria are known to produce the enzyme tyrosinase, which functions as a bioreceptor in electrochemical biosensors that determine antioxidant levels. The tyrosinase enzyme is a monooxygenase enzyme that functions to catalyze the o-hydroxylation of monophenol to diphenol (monophenolase activity) and the oxidation of diphenol to quinone (diphenolase activity) [33].
Based on the results of the research on the tyrosinase enzyme screening test, namely that on the first and second days, there was no clear zone formation in the bacteria, which indicated that the bacteria could produce the tyrosinase enzyme (Figure 3a,b). On the third day, bacteria could produce the tyrosinase enzyme, namely B. megaterium 23, which was characterized by the formation of a clear zone on the media (Figure 3c), in line with the research by Ariyanti [28] which reported that the genus Bacillus could produce the tyrosinase enzyme, which was characterized by the clear zone formation of a tyrosinase enzyme. This clear zone is a form of bacterial defense secreted into the environment. Then, on the fourth day, the media of B. megaterium 23 were seen turning brownish, which means that B. megaterium 23 can produce the tyrosinase enzyme because the tyrosinase enzyme also plays an active role in melanin synthesis, which is in line with previous research which stated that the tyrosinase enzyme can undergo oxidation for melanin formation which is shown in the red line (Figure 3d) [34]. B. megaterium bacteria with isolate codes 55, 6, 53, and 29 cannot produce the tyrosinase enzyme because different bacterial strains produce different amounts and enzymes. The colony shape of B. megaterium bacteria with isolate codes 55, 6, and 53 is irregularly caused by bacterial colonies following growth when etching bacteria on selective media. Therefore, it can be concluded that only B. megaterium 23 produces the tyrosinase enzyme.
Figure 3.
Tyrosinase enzyme screening test from bacteria on (a) day 1, (b) day 2, (c) day 3, and (d) day 4.
3.2.2. Laccase Enzyme Screening
Laccase enzyme screening was carried out to prove that the bacterial isolate could produce the laccase enzyme. The laccase enzyme is an extracellular enzyme found in many plants, bacteria, and fungi. The laccase enzyme catalyzes the oxidation reaction of various phenolic compounds, diamines, and aromatic amines. This is because this enzyme contains multinuclear copper, which utilizes oxygen molecules to oxidize various aromatic compounds.
Observations of the laccase enzyme screening test carried out on laccase media from days 1 to 4 are shown in Figure 4. The laccase enzyme is characterized by a change in color around the colonies to brownish. The first bacterial isolates that changed color were P. fluorescens P4, P5, and P7. Colony color changes in media with guaiacol as a substrate occur due to oxidation and quinone formation reactions from extracellular enzymes. Pseudomonas sp. code 21 bacteria cannot produce the laccase enzyme because the color of the bacterial colonies on the laccase media does not change. This is because the bacteria are no longer active due to the influence of temperature, lack of nutrition, and extended storage of the bacteria. In addition, bacteria of the genus Pseudomonas cannot form spores when nutrients are insufficient, so they cannot survive in unfavorable environments. These results are in line with research by Mandic et al. [27], who researched that Pseudomonas sp. can produce laccase activity, which is characterized by the colony turning brownish.

Figure 4.
Laccase enzyme screening test from bacteria on (a) day 1, (b) day 2, (c) day 3, and (d) day 4.
So, from the results of screening for tyrosinase and laccase enzymes, the candidate bacteria that will be obtained from consortium are B. megaterium 23 and P. fluorescens P4, P5, and P7, and the results of the selection of these bacteria were also selected from observations of bacterial physiological tests.
3.3. Electrochemical Performance of Consortium Bacterial Biofilms
Current selection uses bacterial biofilms selected from enzyme screening tests and bacterial physiological tests using cyclic voltammetry techniques. The analyzer used to evaluate bacterial biofilms is ascorbic acid, which is known to contain natural antioxidants. Ascorbic acid is dissolved in a phosphate buffer solution with pH 7. This phosphate buffer solution can increase electrical energy production and function to help cells maintain pH [35,36]. Phosphate buffer solutions are polar and can be used well as electrolyte solutions that do not produce oxidation peaks in the analyte oxidation potential area and also do not interfere with the analyte oxidation peaks that are formed. Evaluation of electrochemical performance based on bacterial biofilms was carried out on single B. megaterium, single P. fluorescens, and consortium bacteria.
The bacteria from the selection results were made into a consortium, for example, B. megaterium 23 with P. fluorescens P4, B. megaterium with P. fluorescens P5, and B. megaterium with P. fluorescens P7. Immobilization of bacteria into a biofilm for a bacterial consortium is carried out in three ways, such as the B. megaterium 23 consortium being dropped first and then followed by P. fluorescens P4 bacteria (BM 23-P4 external mixing). In the second method, the bacteria P. fluorescens P4 is dropped, and then the drop of B. megaterium 23 is continued (external mixing P4-BM 23). The third method is first to mix the bacteria B. megaterium 23 and P. fluorescens P4 into a microtube with a ratio of 1:1 (mixing in P4-BM 23), and then it is dropped on the surface of the SPCE; likewise, further treatment is performed for bacteria until they form a biofilm. The treatment for making different bacterial consortia is due to needing to find the best mixture of bacteria. Bacteria that live and form biofilms are better than free-living bacteria.
Cyclic voltammetry techniques measure ascorbic acid 0.05 M as a natural antioxidant, producing peak oxidation currents in the potential range of 0.2−0.4. Measurements of single biofilms of B. megaterium and P. fluorescens P4, P5, and P7 produced current values of 0.09 mA, 0.112 mA, 0.103 mA, and 0.105 mA, respectively. Thus, the highest current was obtained by a single bacterial biofilm, namely the P. fluorescens P4 biofilm. However, when the bacteria B. megaterium 23 and P. fluorescens P4 were combined, the current values were, respectively, 0.11 mA (BM 23-P4 external mixing), 0.122 mA (P4-BM 23 external mixing), and 0.114 mA (mixing in P4-BM 23) (Figure 5a). The results obtained by the consortium of B. megaterium 23 and P. fluorescens were unstable due to the lower current value compared to single bacteria. It was caused by B. megaterium 23 and P. fluorescens not synergizing to form a biofilm.

Figure 5.
Evaluation of the current of 0.05 M ascorbic acid on single bacterial biofilms and consortia immobilized on SPCE surfaces in the form of (a) bar graph and (b) cyclic voltammogram. a: B. megaterium 23; b: P. fluorescens P4; c: P. fluorescens P5; d: P. fluorescens P7; e: BM 23-P4 external mixing; f: P4-BM 23 external mixing; g: BM 23-P5 external mixing; h: P5-BM 23 external mixing; i: BM 23-P7 external mixing; j: P7-BM 23 external mixing; k: mixing in P4-BM 23; l: mixing in P5-BM 23; m: mixing in P7-BM 23.
Qualitatively, the highest current at the oxidation peak was obtained by the bacterial consortium in P7-BM 23, namely 0.165 mA, as shown in Figure 5a. The value of the oxidation current of the consortium in P7-BM (mixing in separate microtubes) was higher than single bacterial biofilms in both B. megaterium 23 and P. fluorescens P7. The results obtained can also be seen from the cyclic voltammogram, which is colored red, indicating that the consortium of B. megaterium 23 with P. fluorescens P7 produces the highest oxidation current (Figure 5b). The phosphate buffer electrolyte solution does not show any oxidation peaks, as shown in the dark green cyclic voltammogram in Figure 5b, meaning that the phosphate buffer solution does not interfere with the current value of the sample. The results obtained in this study are in line with the research by Ribeiro et al. [30], who also detected commercial vitamin C, obtaining a peak oxidation current between a potential of 0.2 and 0.4 V. Similarly, ascorbic acid was also detected in the pharmaceutical sector using a cyclic voltammetry technique, with a peak oxidation current in the potential range 0.2−0.4 V and using a pay speed of 100 mV/s [37].
3.4. Optimizing Consortium Biofilm Conditions
Optimization is used to obtain the maximum current response from several treatment functions. Optimization produces different combinations with two treatment factors. This combination produces different current responses for each combination. Response surface methodology (RSM) is a model for studying factors that affect response simultaneously without many trials. The RSM optimization technique is carried out to obtain the best solution from a combination of variables. The advantage of the RSM technique is that it can minimize time, energy, and costs. The treatment functions used in optimization are the phosphate buffer solution’s pH and the biofilm formation time (days). The optimum value obtained for optimizing bacterial biofilm conditions is pH 7, and the time of biofilm formation on the 7th day is based on the contour plot and 3D surface in Figure 6. The maximum current value produced under these conditions is 64.8 µA (red), while the minimum current value obtained is 39.28 (red), as shown in Figure 6. Acidity conditions (pH) also affect the reaction speed because enzymes only work optimally at a certain pH. The contour plot and surface color show the magnitude of the measured oxidation current. Blue indicates the minimum current produced, while red indicates the maximum current in the measurement. The optimum conditions produced will be used as a reference for making biofilms. Each enzyme functions optimally at a certain pH so that the current produced during measurement will vary according to the characteristics of each enzyme.

Figure 6.
Optimum conditions for bacterial biofilms with factors such as biofilm formation time and PBS pH in the form of (a) contour plot and (b) 3D surface.
The optimum time for biofilm formation in this study was the 7th day. This means that on the 7th day, the best biofilm, which adheres to the electrode surface, is formed. Research conducted by Ariyanti [28] showed that the optimum biofilm formation for Bacillus bacteria as producers of the tyrosinase enzyme was on day 6, while research conducted by Chen et al. [38] showed Pseudomonas biofilm formation on day 3. The optimum time for biofilm formation is different because this study used a consortium of bacteria with different characteristics and resistances. These differences in characteristics and resistances could be due to the unique metabolic pathways and growth conditions of each bacterium, which can influence the rate and quality of biofilm formation.
3.5. Surface Characterization of Electrodes Immobilized by Consortium Biofilms
Bacteria can form biofilms from the extracellular polymer matrix secreted into the environment. The matrix comprises proteins, carbohydrates, polysaccharides, water, and DNA [39]. The extracellular polymeric matrix in deeper layers can protect bacterial cells against antimicrobial agents by limiting the diffusion of these antimicrobials. Biofilms can create different environmental conditions; biofilm-forming bacteria can live in environmental conditions lacking nutrients and extreme pH changes. Biofilms can adhere firmly and resist repeated frictional forces. The cells in a biofilm adhere approximately 1000 times more strongly than the planktonic form [40]. Characteristics of the consortium biofilm were established using SEM to determine the morphology of the bacterial consortium biofilm immobilized on the SPCE surface.
Observation of the morphology of bacterial biofilms on day 0: Biofilms had not yet formed because the bacteria had just started attaching randomly to the electrode surface, so what was visible was still a single bacterium. B. megaterium 23 bacteria were marked with a green line, and P. fluorescence P7 bacteria were marked with a yellow color (Figure 7a). Observing the morphology of the bacteria using SEM shows that B. megaterium is characterized by large rod-shaped bacteria with a length of around 4.28 µm, and P. fluorescens P7 bacteria is characterized by round-shaped bacteria with a relatively small size with a diameter of around 1.05 µm; measurement was performed using the Image-J application.

Figure 7.
Characteristics of biofilm formation using a scanning electron microscope (SEM) with a magnification of 10,000 times: (a) 0 days; (b) 7 days; (c) 12 days.
The results of the characterization of the bacterial biofilm on day 7, which is the day for optimum biofilm formation in this study, show that a biofilm has been formed, which is characterized by the gathering of bacteria to form a clustered layer and sticking to the surface of the SPCE (Figure 7b). The results of this study align with research, which states that biofilm formation is characterized by a layer film of bacteria that gathers on the surface [41,42]. The layer film is formed because the bacteria have secreted an extracellular polymer matrix on the surface of the fusion of two bacteria. Then, on the 12th day, it can be seen that a bacterial biofilm has formed, which is characterized by a large layer covering the electrode surface, which can be seen in Figure 7c. Thus, it can be concluded that the bacterial consortium of B. megaterium 23 and P. fluorescens P7 can form a biofilm with a widespread layer of bacteria on the electrode surface with different colonization abilities. The number of bacterial colonies produced by B. megaterium 23 was 2 × 106 cfu/mL, while the number of bacterial colonies produced by P. fluorescens P7 was 91.4 × 108 cfu/mL.
3.6. Biosensor Analytical Performance
The compound used to evaluate analytical performance is catechol because it is used as a substrate for measuring antioxidant capacity. The linearity produced in this study follows the linear regression equation y = 0.04x + 1.9548 with a coefficient of determination (R2) = 0.992 (Figure 8). The biomaterial used is agarose, which is dropped after bacteria are immobilized on the electrode surface; agarose is a natural polysaccharide polymer biomaterial, gel plate, or layer for cells in tissue culture and cell culture media, and its excellent biocompatibility, thermo-reversible gelation behavior, and physiochemical features support its use as biomaterials for cell growth [43].

Figure 8.
Linearity of catechol concentration current in the range 10–300 µM.
The resulting cyclic voltammogram shows that the higher the substrate concentration, the more the peak oxidation current also increases. The resulting sensitivity is 0.04 µAµM−1, which means that for every change in the analyte concentration value of 1 µM, there is a change in the current response of 0.04 µA on biosensors. This study’s detection limit and quantitation limit were 0.5 µM and 10 µM, respectively. The LOD resulting from this research is better than previous research that used the superoxide dismutase (SOD) enzyme to detect antioxidants, namely 40.8 µM [44]. The stability of the biosensor was also measured using a catechol 150 µM solution, and the response was stable until the 10th week, with a value of 95.34% (Figure 9). Han et al. [45] conducted research that used consortium biofilms from Arthrobacter sp. and Streptomyces sp., which survived for 90 days. In addition, the bacterial consortium biofilm of Comamonas sp. and Hyphomicrobium sp. was stable when measured on day 15 [46]. The repeatability of measurements of catechol compounds was determined using five SPCE electrodes that consortium biofilms had immobilized. The results show that the electrode has good replicability with an RSD value of <5%, namely 2.08%.

Figure 9.
Biosensor stability after 10 weeks of measurements with 150 µM of catechol.
3.7. Antioxidant Capacity Using Biosensor and DPPH Methods
Standard ascorbic acid as a natural antioxidant was measured using a biosensor and the DPPH method as a reference. The standard curve produced by the biosensor method shows the relationship between current and concentration with the regression equation y = 0.0187x + 0.1593 with R2 = 0.9998. The standard curve produced by the DPPH method shows that the relationship between Δ absorbance and concentration produces a regression equation y = 0.0074x + 0.1045 with R2 = 0.9998, which means that the standard measurement of ascorbic acid using a biosensor with DPPH has good linearity.
The results of the antioxidant capacity were obtained from the five extracts using the DPPH method from highest to lowest: Psidium guajava extract > Curcuma xanthorriza > Phyllanthus niruri > Orthosiphon stamineus > Sonchus arvensis. The biosensor method used the highest to lowest antioxidant capacity, namely Psidium guajava extract > Phyllanthus niruri > Curcuma xanthorriza > Orthosiphon stamineus > Sonchus arvensis. The antioxidant capacity values of the two methods were compared and analyzed using two-way ANOVA, followed by the Duncan test using the SmartstatXL application with a 95% confidence interval. The exported values are the mean ± SD of four assays for each sample. The results obtained from the five plant extracts showed significantly different antioxidant capacities (p < 0.05), as seen in Table 1.

Table 1.
Antioxidant capacity using biosensor and DPPH methods.
The differences in antioxidant capacity results between samples are due to differences in the content of flavonoids, phenolic compounds, and their derivatives in each extract. However, these two methods have similar values regarding the resulting antioxidant capacity. There was no significant difference in the antioxidant capacity values in the Psidium guajava, Orthosiphon stamineus, and Sonchus arvensis extract samples from the antioxidant capacity values using the biosensor or DPPH method. The highest antioxidant capacity value in the biosensor method, namely Psidium guajava extract, is 0.2625 mmol AAE/g extract, which is in line with the DPPH method with an antioxidant capacity value of Psidium guajava extract of 0.2780 mmol AAE/g extract. Guava extract contains tannins, alkaloids, phenolics, and quercetin as flavonoid compounds [47]. Flavonoid and phenolic compounds have hydroxyl groups that function to capture free radicals. So, the more hydroxyl groups contained in a compound, the greater the antioxidant content. The hydroxyl group’s ortho-position significantly influences a flavonoid’s antioxidant capacity. The results of measurements using the biosensor and DPPH methods can differentiate the antioxidant capacity values of the five extract samples marked with lowercase letters, as shown in Table 1.
Differences in the results of antioxidant capacity are also influenced by the mechanism of each method [6]. The mechanism in the DPPH method, measuring antioxidant capacity, depends on the transfer of hydrogen from antioxidant molecules to DPPH radicals and the type of solvent involved. DPPH radicals are dark purple; the color will change to yellow if the radical receives electrons or hydrogen from antioxidant molecules during testing. Meanwhile, biosensors are based on measuring redox currents at a particular potential catalyzed by enzymes. In a typical reaction catalyzed by laccase and tyrosinase, the phenolic substrate undergoes single-electron oxidation to produce the oxidation of o-diphenol to o-quinone (catecholase activity). A reversible redox reaction between oxygen and hydrogen will produce electrons. Electrons transfer to the transducer in the form of a signal. Then, this signal is converted into electromagnetic waves, which can be read and recorded as oxidation current peaks. The consortium biofilm-based biosensor that produces the tyrosinase–laccase enzyme is assumed to have more electron transferring as a result of the catalytic reaction of the two enzymes.
There are differences in the measurement results of the two methods, namely Curcuma xanthorriza extract and Orthosiphon stamineus. The color of the sample influences measurements using the DPPH method; samples containing antioxidants will turn yellow after dripping the DPPH solution, but the original color of the Curcuma xanthorriza extract sample is yellow; this is a notable concern, namely the absorbance of the color of the extract, and for this reason, color correction of the measurements is required. According to the research by Rodrí [48] in determining antioxidant capacity, which also uses catechol as a substrate when compared with standard methods, it produces significantly different values. However, this method has different characteristics and advantages, too. Thus, this consortium’s biofilm-based biosensor method can be developed to determine antioxidant capacity because it can differentiate the capacity of the five sample extracts.
4. Conclusions
From the results obtained, B. megaterium can produce the tyrosinase enzyme, and P. fluorescens can produce the laccase enzyme, and these two bacteria were successfully combined to form a biofilm. Consortium biofilms were selected based on the highest current response evaluated electrochemically with cyclic voltammetry analysis techniques. The highest current results were obtained from the B. megaterium 23 and P. fluorescens P7 consortium biofilm mixed in a microtube ratio (1:1) with a current value of 0.165 mA. Consortium biofilm optimization results were obtained in phosphate buffer with a pH of 7 and biofilm formation on day 7. The analytical performance of the biosensor was evaluated over a concentration range of 10–300 µM, resulting in the regression equation y = 0.04x + 1.9548 with R2 = 0.992. The LOD and LOQ values are 0.5 µM and 10 µM, respectively. Biosensor repeatability showed RSD < 5%. The biosensor showed a stable response until the 10th week. The antioxidant capacity measured in the five extracts by both methods differed significantly (p < 0.05). However, the antioxidant capacity values of the five extracts measured by both methods showed the same trend. The highest antioxidant capacity is guava extract, and the lowest is tempuyung extract. Thus, this biosensor method can be used as an alternative for measuring antioxidant capacity.
5. Discussion and Suggestion
This research is the first step in identifying antioxidant polyphenols by developing a biosensor method that uses a combination of two bacteria as bioreceptors. To improve the performance of this research, it is necessary to optimize the number of bacteria in a sample (CFU), measure selectivity with various non-phenolic compounds, and evaluate the analytical performance of biosensors using ascorbic acid as the standard.
Author Contributions
Conceptualization, R.M.S.; Methodology, R.M.S., N.N. and M.R.; Software, R.M.S.; Validation, D.I. and M.R.; Data curation, D.I.; Writing—original draft, R.M.S.; Writing—review & editing, D.I., N.N. and M.R.; Visualization, R.M.S. and D.I.; Supervision, D.I., N.N. and M.R. All authors have read and agreed to the published version of the manuscript.
Funding
This research was funded by Directorate General Higher Education, Research, and Technology, The Ministry Education, Culture, Research, and Technology, Republic of Indonesia, for research funding in the scheme Regular Fundamental Research fiscal year 2024 with grant number 22026/IT3.D10/PT.01.03/P/B/2024.
Institutional Review Board Statement
Not applicable.
Informed Consent Statement
Not applicable.
Data Availability Statement
All data included in this study are available upon request by contact with the corresponding author.
Conflicts of Interest
The authors declare no conflicts of interest.
References
- Sukma, R.M.; Iswantini, D.; Nurhidayat, N.; Rafi, M. Antioxidant Determining Using Electrochemical Method. Chemistry 2023, 5, 1921–1941. [Google Scholar] [CrossRef]
- Rafi, M.; Febriany, S.; Wulandari, P.; Suparto, I.H.; Ridwan, T.; Rahayu, S.; Siswoyo, D.M. Total phenolics, flavonoids, and anthocyanin contents of six Vireya Rhododendron from Indonesia and evaluation of their antioxidant activities. J. Appl. Pharm. Sci. 2018, 8, 49–54. [Google Scholar] [CrossRef]
- Rafi, M.; Wahyuni, W.T.; Arif, Z.; Heryanto, R. Authentication of Orthosiphon Aristatus Using a Combination of Ultraviolet-Visible Spectrum and Partial Least Square Regression. Indones. J. Cheometrics Pharm. Anal. 2021, 1, 93–101. [Google Scholar]
- Parisa, N.; Kamaluddin, M.T.; Saleh, M.I.; Sinaga, E.; Partan, R.U. Flavonoids as Antioxidants: A Review on Tempuyung Plant (Sonchus arvensis). J. Med. Chem. Sci. 2023, 6, 2310–2318. [Google Scholar]
- Naseer, S.; Hussain, S.; Naeem, N.; Pervaiz, M.; Rahman, M. The phytochemistry and medicinal value of Psidium guajava (guava). Clin. Phytosci. 2018, 4, 32. [Google Scholar] [CrossRef]
- Alnsour, L.; Issa, R.; Awwad, S.; Albals, D.; Al-Momani, I. Quantification of total phenols and antioxidants in coffee samples of different origins and evaluation of the effect of degree of roasting on their levels. Molecules 2022, 27, 1591. [Google Scholar] [CrossRef]
- Zhang, M.Q.; Zhang, J.; Zhang, Y.T.; Sun, J.Y.; Prieto, M.A.; Simal-Gandara, J.; Putnik, P.; Li, N.-Y.; Liu, C. The link between the phenolic composition and the antioxidant activity in different small berries: A metabolomic approach. LWT 2023, 182, 114853. [Google Scholar] [CrossRef]
- Li, Y.; Si, D.; Sabier, M.; Liu, J.; Si, J.; Zhang, X. Guideline for screening antioxidant against lipid-peroxidation by spectrophotometer. eFood 2023, 4, e80. [Google Scholar] [CrossRef]
- Tatarczak-Michalewska, M.; Flieger, J. Application of High-Performance Liquid Chromatography with Diode Array Detection to Simultaneous Analysis of Reference Antioxidants and 1,1-Diphenyl-2-picrylhydrazyl (DPPH) in Free Radical Scavenging Test. Int. J. Environ. Res. Public Health 2022, 19, 8288. [Google Scholar] [CrossRef]
- Zhou, X.; Power, D.; Jones, A.; Acquaviva, A.; Dennis, G.R.; Shalliker, R.A.; Li, C.; Soliven, A. Antioxidant Profiling of Ginger via Reaction Flow Chromatography. Nat. Prod. Commun. 2021, 16, 1934578X2110352. [Google Scholar] [CrossRef]
- Hayes, P.E.; Luong, J.H.T.; Gilchrist, E.S.; Buzid, A.; Glennon, J.D. Profiling of phenolic flavorings using core-shell reversed-phase liquid chromatography with electrochemical detection at a boron-doped diamond electrode. J. Chromatogr. A 2020, 1612. [Google Scholar] [CrossRef] [PubMed]
- Timchenko, Y.V. Advantages and Disadvantages of High-Performance Liquid Chromatography (HPCL). J. Environ. Anal. Chem. 2021, 8, 2391. [Google Scholar]
- Wang, X.; Zhou, J.; Wang, H. Bioreceptors as the key components for electrochemical biosensing in medicine. Cell Rep. Phys. Sci. 2024, 5, 101801. [Google Scholar] [CrossRef]
- Wijayanti, S.D.; Tsvik, L.; Haltrich, D. Recent Advances in Electrochemical Enzyme-Based Biosensors for Food and Beverage Analysis. Foods 2023, 12, 3355. [Google Scholar] [CrossRef]
- Iswantini, D.; Nurhidayat, N.; Trivadila; Widyatmoko, O. Activity and stability of uricase from Lactobacillus plantarum was Immobilizated on Natural Zeolite for Uric Acid Biosensor. Pak. J. Biol. Sci. 2014, 17, 277–281. [Google Scholar] [CrossRef]
- Haleem, A.; Javaid, M.; Singh, R.P.; Suman, R.; Rab, S. Biosensors applications in medical field: A brief review. Sens. Int. 2021, 2, 100100. [Google Scholar] [CrossRef]
- Ye, Y.; Ji, J.; Sun, Z.; Shen, P.; Sun, X. Recent advances in electrochemical biosensors for antioxidant analysis in foodstuff. TrAC-Trends Anal. Chem. 2020, 122, 115718. [Google Scholar] [CrossRef]
- Wu, L.; Yin, W.; Tang, K.; Li, D.; Shao, K.; Zuo, Y.; Ma, J.; Liu, J.; Han, H. Enzymatic biosensor of horseradish peroxidase immobilized on Au-Pt nanotube/Au-graphene for the simultaneous determination of antioxidants. Anal. Chim. Acta 2016, 933, 89–96. [Google Scholar] [CrossRef]
- Munteanu, I.G.; Apetrei, C. Tyrosinase-Based Biosensor—A New Tool for Chlorogenic Acid Detection in Nutraceutical Formulations. Materials 2022, 15, 3221. [Google Scholar] [CrossRef]
- De Oliveira Neto, J.R.; Rezende, S.G.; Lobón, G.S.; Garcia, T.A.; Macedo, I.Y.L.; Garcia, L.F.; Alves, V.F.; Torres, I.M.S.; Santiago, M.F.; Schmidt, F.; et al. Electroanalysis and laccase-based biosensor on the determination of phenolic content and antioxidant power of honey samples. Food Chem. 2017, 237, 1118–1123. [Google Scholar] [CrossRef]
- Martinez-Perez, C.; Ward, C.; Cook, G.; Mullen, P.; McPhail, D.; Harrison, D.J.; Langdon, S.P. Novel flavonoids as anti-cancer agents: Mechanisms of action and promise for their potential application in breast cancer. Biochem. Soc. Trans. 2014, 42, 1017–1023. [Google Scholar] [CrossRef] [PubMed]
- Wijayanti, I.E. Comparison of Optimization of Antioxidant Biosensors Using Pure Superoxide Dismutase Extracts and Enzymes. EduChemia 2016, 1, 1–13. [Google Scholar]
- Iswantini, D.; Nurhidayat, N.; Abidin, Z. Antioxidant biosensor based on superoxide dismutase from Indonesian microbes immobilized in Indonesian natural zeolite. J. Appl. Pharm. Sci. 2019, 9, 104–109. [Google Scholar]
- Montereali, M.R.; Della Seta, L.; Vastarella, W.; Pilloton, R. A disposable Laccase—Tyrosinase based biosensor for amperometric detection of phenolic compounds in must and wine. J. Mol. Catal. B Enzym. 2010, 64, 189–194. [Google Scholar] [CrossRef]
- Alvarado-Ramírez, L.; Rostro-Alanis, M.; Rodríguez-Rodríguez, J.; Sosa-Hernández, J.E.; Melchor-Martínez, E.M.; Iqbal, H.M.N.; Parra-Saldívar, R. Enzyme (Single and multiple) and nanozyme biosensors: Recent developments and their novel applications in the water-food-health nexus. Biosensors 2021, 11, 410. [Google Scholar] [CrossRef]
- Sun, G.; Wei, X.; Zhang, D.; Huang, L.; Liu, H.; Fang, H. Immobilization of Enzyme Electrochemical Biosensors and Their Application to Food Bioprocess Monitoring. Biosensors 2023, 13, 886. [Google Scholar] [CrossRef]
- Mandic, M.; Djokic, L.; Nikolaivits, E.; Prodanovic, R.; O’connor, K.; Jeremic, S.; Topakas, E.; Nikodinovic-Runic, J. Identification and characterization of new laccase biocatalysts from Pseudomonas species suitable for degradation of synthetic textile dyes. Catalysts 2019, 9, 2–14. [Google Scholar] [CrossRef]
- Ariyanti, D. Highly Sensitive Phenol Biosensor Utilizing Selected Bacillus Biofilm Through an Electrochemical Method. Makara J. Sci. 2020, 24, 24–30. [Google Scholar]
- Campanella, L.; Martini, E.; Tomassetti, M. Antioxidant capacity of the algae using a biosensor method. Talanta 2005, 66, 902–911. [Google Scholar] [CrossRef]
- Ribeiro, D.B.; Silva, G.S.; Dos Santos, D.R.; Costa, A.R.C.; Ribeiro, E.B.; Badea, M.; Nunes, G.S. Determination of the antioxidant activity of samples of tea and commercial sources of vitamin c, using an enzymatic biosensor. Antioxidants 2021, 10, 324. [Google Scholar] [CrossRef]
- Panjaitan, F.J.; Bachtiar, T.; Arsyad, I.; Lele, O.K.; Indriyani, W. Karakterisasi Mikroskopis dan Uji Biokimia Bakteri Pelarut Fosfat (BPF) dari Rhizosfer Tanaman Jagung Fase Vegetatif. J. Ilmu Pertan Dan Lingkung 2020, 1, 9–17. [Google Scholar]
- Damayanti, S.S.; Komala, O.; Effendi, E.M. Identifikasi Bakteri Dari Pupuk Organik Cair Isi Rumen Sapi. Ekologia 2020, 18, 63–71. [Google Scholar] [CrossRef]
- El-Nashar, H.A.S.; El-Din, M.I.G.; Hritcu, L.; Eldahshan, O.A. Insights on the inhibitory power of flavonoids on tyrosinase activity: A survey from 2016 to 2021. Molecules 2021, 26, 7546. [Google Scholar] [CrossRef]
- Elsayed, E.A.; Danial, E.N. Isolation, identification and medium optimization for tyrosinase production by a newly isolated Bacillus subtilis NA2 strain. J. Appl. Pharm. Sci. 2018, 8, 93–101. [Google Scholar]
- Song, C.; Liu, H.; Zhang, L.; Wang, J.; Zhao, C.; Xu, Q.; Yao, C. FeS nanoparticles embedded in 2D carbon nanosheets as novel nanozymes with peroxidase-like activity for colorimetric and fluorescence assay of H2O2 and antioxidant capacity. Sens. Actuators B Chem. 2022, 353, 131131. [Google Scholar] [CrossRef]
- Pavani, P.; Kumar, K.; Rani, A.; Venkatesu, P.; Lee, M.J. The influence of sodium phosphate buffer on the stability of various proteins: Insights into protein-buffer interactions. J. Mol. Liq. 2021, 331, 115753. [Google Scholar] [CrossRef]
- Amayreh, M.; Hourani, W.; Hourani, M.K. Voltammetric determination of ascorbic acid in pharmaceutical formulations using modified iodine-coated platinum electrode. Rev. Vitae 2021, 28. [Google Scholar] [CrossRef]
- Chen, X.; Thomsen, T.R.; Winkler, H.; Xu, Y. Influence of biofilm growth age, media, antibiotic concentration and exposure time on Staphylococcus aureus and Pseudomonas aeruginosa biofilm removal in vitro. BMC Microbiol. 2020, 20, 264. [Google Scholar] [CrossRef]
- Wang, Y.; Zhang, R.; Duan, J.; Shi, X.; Zhang, Y.; Guan, F.; Sand, W.; Hou, B. Extracellular Polymeric Substances and Biocorrosion/Biofouling: Recent Advances and Future Perspectives. Int. J. Mol. Sci. 2022, 23, 5566. [Google Scholar] [CrossRef]
- Vestby, L.K.; Grønseth, T.; Simm, R.; Nesse, L.L. Bacterial biofilm and its role in the pathogenesis of disease. Antibiotics 2020, 9, 59. [Google Scholar] [CrossRef]
- Verdier, T.; Bertron, A.; Erable, B.; Roques, C. Bacterial biofilm characterization and microscopic evaluation of the antibacterial properties of a photocatalytic coating protecting building material. Coatings 2018, 8, 93. [Google Scholar] [CrossRef]
- Gomes, L.C.; Mergulhão, F.J. SEM analysis of surface impact on biofilm antibiotic treatment. Scanning 2017, 1, 2960194. [Google Scholar] [CrossRef] [PubMed]
- Febryanti, A.; Mulijani, S.; Iswantini, D.; Nurhidayat, N. Antioxidant Biosensor based on Deinococcus radiodurans Biofilm immobilized on Screen-printed Carbon Electrode (SPCE) Surface. Int. J. Res. Appl. Sci. Biotechnol. 2018, 5, 1–7. [Google Scholar]
- Salati, M.A.; Khazai, J.; Tahmuri, A.M.; Samadi, A.; Taghizadeh, A.; Taghizadeh, M.; Zarrintaj, P.; Ramsey, J.D.; Habibzadeh, M.; Seidi, F.; et al. Agarose-Based biomaterials: Opportunities and challenges in cartilage tissue engineering. Polymers 2020, 12, 1150. [Google Scholar] [CrossRef]
- Han, Y.N.; Wei, M.; Han, F.; Fang, C.; Wang, D.; Zhong, Y.J.; Guo, C.-L.; Shi, X.-Y.; Xie, Z.-K.; Li, F.-M. Greater biofilm formation and increased biodegradation of polyethylene film by a microbial consortium of Arthrobacter sp. and Streptomyces sp. Microorganisms 2020, 8, 1979. [Google Scholar] [CrossRef] [PubMed]
- Horemans, B.; Hofkens, J.; Smolders, E.; Springael, D. Biofilm formation of a bacterial consortium on linuron at micropollutant concentrations in continuous flow chambers and the impact of dissolved organic matter. FEMS Microbiol. Ecol. 2014, 88, 184–194. [Google Scholar] [CrossRef]
- Hartati, R.; Nadifan, H.I.; Fidrianny, I. Crystal Guava (Psidium guajava L. “crystal”): Evaluation of in Vitro Antioxidant Capacities and Phytochemical Content. Sci. World J. 2020, 2020, 9413727. [Google Scholar] [CrossRef]
- Rodrí, E. Electrochemical Quantification of the Antioxidant Capacity of Medicinal Plants Using Biosensors. Sensors 2014, 14, 14423–14439. [Google Scholar] [CrossRef] [PubMed]
Disclaimer/Publisher’s Note: The statements, opinions and data contained in all publications are solely those of the individual author(s) and contributor(s) and not of MDPI and/or the editor(s). MDPI and/or the editor(s) disclaim responsibility for any injury to people or property resulting from any ideas, methods, instructions or products referred to in the content. |
© 2024 by the authors. Licensee MDPI, Basel, Switzerland. This article is an open access article distributed under the terms and conditions of the Creative Commons Attribution (CC BY) license (https://creativecommons.org/licenses/by/4.0/).